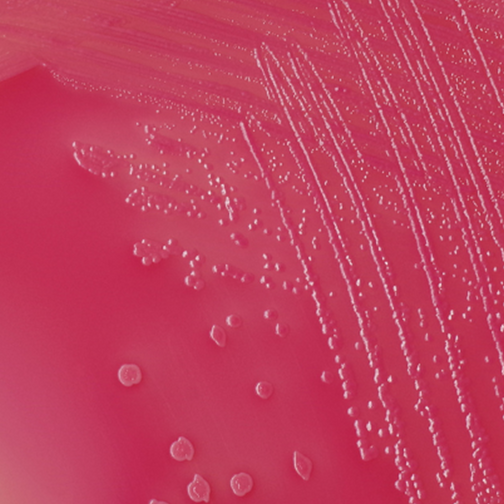

Vitamin B12 Chewables
No Fillers
No Artificial Additives
No Gluten
No Dairy
No Artificial Sweeteners
No Added Sugar
No Stevia
Made with
Performance Enhancing Plants™
1,500 mcg of bioactive, methylated plant-based Vitamin B12

Vitamin B12 (as Methylcobalamin)
Methylcobalamin
Feel the difference
| Other Brands | ||
|---|---|---|
| Certified USDA Organic | ||
| Certified vegan source of Vitamin B12 | ||
| Uses the bioactive form of Vitamin B12 for better absorption and bioactivity | ||
| Easy-to-take chewable tablet | ||
| No Stevia or added sugar | ||
| Third-party tested and results shared publicly |
Frequently Asked
When should I take my Buzzy B12?
Do I need to take Buzzy B12 with food?
Can I take Buzzy B12 if I’m pregnant or breastfeeding?
Can my kids take Buzzy B12?


